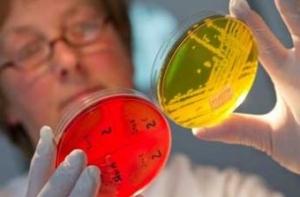
Найден источник распространения смертельно опасной кишечной бактерии: это не овощи

Читайте нас также
Немецкие ученые разработали экспресс-тест для выявления «овощной» кишечной инфекции. Число жертв E.coli выросло до 36 человек
Экспресс-тест по выявлению кишечной инфекции, унесшей 36 жизней, разработали германские ученые из Института гигиены университетской клиники города Мюнстер.
Тест есть уже во всех лабораториях, которые работают по эпидемии кишечной палочки E.coli 0104, сообщает ИТАР-ТАСС со ссылкой на руководителя исследования профессора Хелге Карха.
Говоря о перспективах борьбы с инфекцией ученый сказал: «Я надеюсь, что вирус сам прекратит существование как источник потенциальной угрозы. Но он может достаточно долго - до года - сохраняться в «спящем» состоянии в организме человека и в окружающей среде. Поэтому есть риск, что возбудитель может вновь вернуться».
«Даже если источник заразы будет локализован, вирус сможет размножаться в продуктах питания».
Профессор сообщил, что «эксперты Института Роберта Коха, занимающиеся в Германии исследованием образцов пищевых продуктов, объявили, что все-таки нашли источник опасных бактерий».

«Все тесты показывают, что непосредственное отношение к распространению кишечной палочки имеют пророщенные злаки, - отметил он. - Подозрения с огурцов, помидоров и салата официально сняты».
Между тем в Германии число умерших от кишечной инфекции, вызванной бактерией E.coli, возросло до 36, передает радио «Свобода».
В воскресенье германский Федеральный институт оценки рисков для населения назвал эту вспышку инфекции самой масштабной из всех подобных, зарегистрированных до сих пор в мире.
Число инфицированных либо пациентов с подозрением на инфекцию в Германии достигло 4 тыс. человек. Большинство заболевших в других странах посещали ФРГ.
На сегодняшний день сообщается лишь о 5 случаях болезни, не связанных с посещением Германии, напоминает «Росбалт».
В Германии у почти ста выздоровевших пациентов болезнь вызвала серьезные нарушения функции почек, которые могут на долгие годы отразиться на их здоровье.
Накануне лабораторные исследования экспертов из Федерального института оценки рисков подтвердили данные о наличии бактерии серотипа 0104:H4 на ростках бобовых культур, произведенных на ферме, расположенной в Биненбюттеле.
Таким образом, подтвердилась основная версия, что именно пророщенные семена бобовых с этого сельхозпредприятия являются источником инфекции.